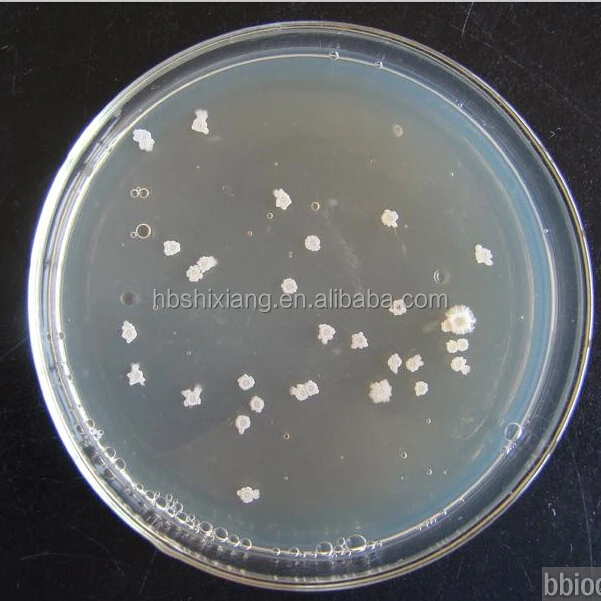

Активный Сенная палочка
- Категория: Кормовые антибиотики и антибактериальные агенты >>>
- Поставщик: Hebei,Shixiang,Biological,Technology,Co.,Ltd.
Поделиться:
Описание и отзывы
Трекер стоимости
| Месяц | Минимальная цена | Макс. стоимость |
|---|---|---|
| Sep-20-2025 | 0.61 $* | 0.66 $* |
| Aug-20-2025 | 0.94 $* | 0.95 $* |
| Jul-20-2025 | 0.92 $* | 0.16 $* |
| Jun-20-2025 | 0.65 $* | 0.17 $* |
| May-20-2025 | 0.93 $* | 0.97 $* |
| Apr-20-2025 | 0.65 $* | 0.77 $* |
| Mar-20-2025 | 0.43 $* | 0.42 $* |
| Feb-20-2025 | 0.16 $* | 0.75 $* |
| Jan-20-2025 | 0.10 $* | 0.33 $* |
Характеристики
Bacillus Subtilis Water Additives
(Multi-functional Probiotics Bacillus Subtilis)
I. Brief Introduction:
The series products are refined green microbial multi-functional probiotic feed additives, extracted from deep liquid fermentation of Bacillus Subtilis, which is breeded by special process. This series products are avirulent, harmless, no residues, no pollution and the effect is remarkable, which is the best choice for green healthy and environment friendly breeding. It is widely applied in feed additives of poultry, livestock, aquatic animals, ruminants and etc.
II. Product Functions:
1. Adjust effectively micro-ecology bacteria group balance in animal gut, restrain the growth of colibacillus, salmonella and other harmful bacteria and promote the growth of beneficial bacteria breeding, such as lactobacillus, bifidobacterium and etc.
2. Improve animal immunity; reduce animal morbidity and the dosage of antibiotic.
3. Increase digestion utilization rate of feed, promote animal growth, reduce feed dosage and improve the feed efficiency.
4. Reduce excretion of ammonia and nitrogen in animal waste, decrease the concentration of harmful gas in breeding place for livestock and poultry, improve the breeding condition and reduce environment pollution.
III. Mechanism:
This Series of products compete with harmful bacterium for the attachment points in digestive tract, produce antibacterial material, and compete with harmful bacteria to get nutrients, strive for oxygen by biological mechanisms ,thereby, establish normal microflora in digestive tract; adjust and improve immune function; improve digestion and absorption function; prevent toxic amine synthesized.
IV. Product Features:
1. The strains are safety strains which are listed on "feed additive varieties directory" issued by the Ministry of Agriculture; breeded by special submerged fermentation process, especially meet the animal breeding need in domestic and overseas.
2. Refined and extracted by deep ventilation liquid fermentation process with high content of CFU, and no miscellaneous bacteria.
3. Good stability.
4. Available in many kinds of strong enzyme activit.
5. Provides vitamin nutrition for animals.
6. Safety, green, and non-toxic without pollution and side effects.
V. Characteristics:
Appearance: yellow-brown powder
Odor: slight fermentation odor
Specification: 20 billion cfu/g, 50 billion cfu/g, 100 billion cfu/g
Loss on Drying: ≤ 8%
Particle Size: ≥ 80% pass 40 mesh
VI. Reference Dosage:
(The following dosage is an example of BS200. Other products can be converted according to the content of CFU)
| Animal Species | Dosage (g/ton of feed) |
| Piglet | 200--300 |
| Middle and Big Pig | 100--200 |
| Breeding/Egg Poultry | 150--200 |
| Meat Poultry | 150--200 |
| Ruminant | 200--300 |
| Aquatic Aniaml | 300--500 |
For animal drinking water: in proportion 1:250 to 1:500 (for example, 1 Ton water need 2-4KG), wrapped with gauze and immersed in water for hours, then squeeze the gauze dry, finally add this liquid to animal drinking water.
VII. Storage:
Should be stored in a cool, dry and well-ventilated place; protect from direct sunlight, heat and dampness; avoid storing with poisonous and harmful substances.
VIII. Shelf Life:
The product remains ≥ 90% of the indicated content of CFU after 12 months at room temperature 25°C.
IX. Technical Support and Service:
Xingtai Sinobest Biotech Co., Ltd. will provide technical support service in the whole process. Our professional technicians will guarantee every client to use this product under proper guide.
Package & Storage:
Usually is 25kg drum. it's suitable for long term transportation and tightly enough.
Shelf life: 12 month with well storage.
Notice: This product is easy to absorb moisture, please store in a cold, dry and ventilated place.
OEM packing is acceptable and other packings as required. Meet customers's demand is our standards.
Shipping:
Handling Time: Usually within 10 days after the confirmation
Shipment: by sea or by air
Payment: T/T, L/C, West Union or other terms for negotiating
Sample: available (1 days after confirmed)
Quality Contral:
The company has passed the ISO9000 quality management system certification. We have fist -class equipment and strict quality management system.
We got our own Testing Lab to make sure the qualilty follow up with the related standar. Each lot of the produts will be strictly and carefully inspected before they leave the factory.
Contant: